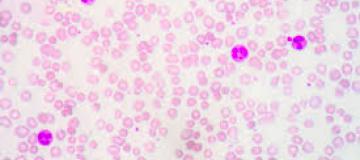

Conferenza Scientifica: Prof.ssa Lucia Catani - 16/12/2016 - Aula Castellino ore 14.00
Presso l'Aula Castellino p.t. Palazzina Ambulatori, venerdì 16 dicembre 2016 alle ore 14.00 avrà luogo la Conferenza Scientifica organizzata nell'ambito del corso di Dottorato di Ricerca in Scienze Cliniche e Sperimentali
dal titolo: "Inflammatory Microenvironment In Myeloproliferative Neoplasms: The Hemopoietic Stem/Progenitor Cells And Immune Cells Point Of View
Relatore: Prof.ssa Lucia Catani dell'Istituto di Ematologia “L. e A. Seràgnoli”, Università degli Studi di Bologna.